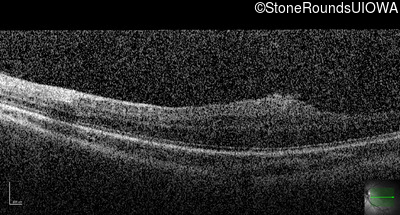
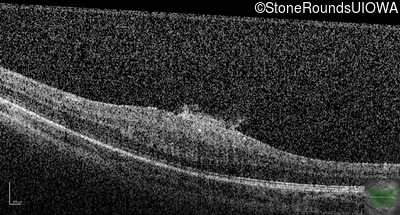
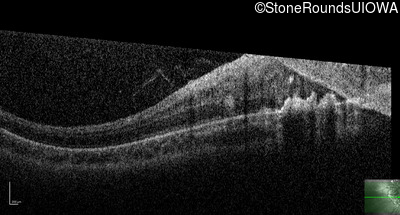
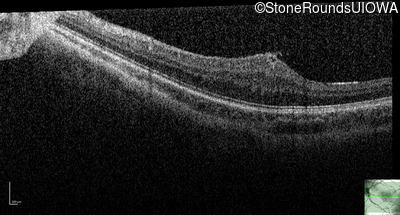
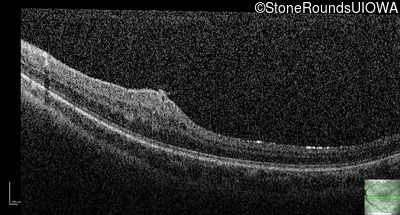
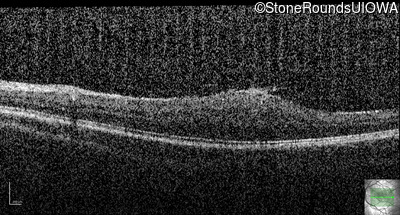
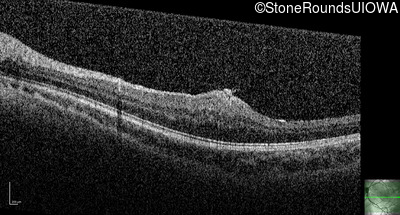
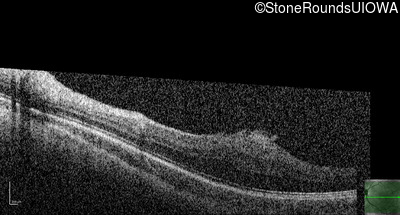
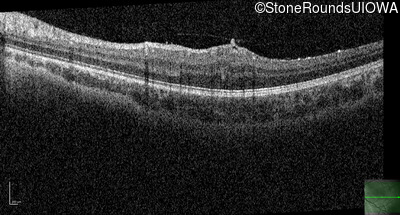
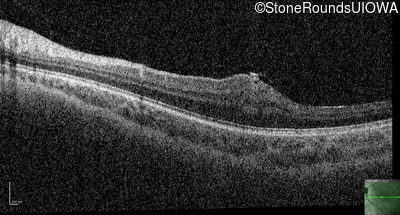

Case
SR2246
Student Mode
Neurofibromatosis (IIID5b)
Male
Male
Hidden
SR2246
Student Mode
Neurofibromatosis (IIID5b)
Male
Male
History
This 9 year old male was noted to have some crossing of his eyes at 2 months of age and the eye exam which followed identified a retinal lesion in the right eye. When he was six years old an epiretinal membrane was noted in his left eye. Two years later it was decided that it was a thin hamartoma in that eye as well. He underwent neuroimaging at age 7 which identified bilateral acoustic neuromas.
| Age at visit: 4 months |
| OD | |||
|---|---|---|---|
| Age at visit: 7 years |
| Age at visit: 8 years |
| Age at visit: 10 years |
| Age at visit: 11 years |
| Age at visit: 14 years |
Diagnosis & molecular findings
| Disease | Gene | Allele 1 variant(s) | Allele 2 variant(s) | Inheritance mode |
|---|---|---|---|---|
| Neurofibromatosis | NF2 | Trp258 del1tG | AD |